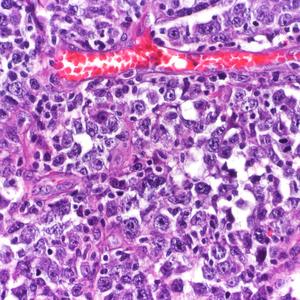
DLBCL_008ate

Cytometry
Stephen J. Kroos

Cytometry
Used Short

フローサイトメトリー
Yukka

Heavy Metal Cytometry
The Legendeers

DLBCL_008ate
ClinicalFlowCytometry

DLBCL_005
ClinicalFlowCytometry

DLBCL_001a.
ClinicalFlowCytometry

normal 28 3 0219
ClinicalFlowCytometry

normal 27 8 0216
ClinicalFlowCytometry

normal 27 4 0212
ClinicalFlowCytometry

normal 27 2 0210
ClinicalFlowCytometry

normal 27 6 0214
ClinicalFlowCytometry

normal 27 5 0213
ClinicalFlowCytometry

aml 101 2 0808
ClinicalFlowCytometry

DLBCL_009nine
ClinicalFlowCytometry

normal 27 7 0215
ClinicalFlowCytometry

aml 101 2 0818
ClinicalFlowCytometry

aml 101 2 0817
ClinicalFlowCytometry

aml 101 2 0807
ClinicalFlowCytometry

aml 101 2 0806
ClinicalFlowCytometry

aml 101 2 0802
ClinicalFlowCytometry

aml 101 1 0801
ClinicalFlowCytometry

DLBCL_003a.
ClinicalFlowCytometry

DLBCL_00Six
ClinicalFlowCytometry

DLBCL_002a.
ClinicalFlowCytometry

DLBCL_00(4)
ClinicalFlowCytometry

normal 28 2 0218
ClinicalFlowCytometry

normal 28 1 0217
ClinicalFlowCytometry

normal 27 3 0211
ClinicalFlowCytometry
DLBCL_010ten
ClinicalFlowCytometry